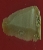

| Title | Reference Number | Provenance | State | Photographs |
| Core | UM-DCP-MH-651807 | Mahurjhari MHR , District Nagpur, Maharashtra | Maharashtra |  |
| Blade | OT-EXB-DL-1034997 | Dholavira, Dist.- Kutch, Gujarat | Delhi |  |
| Utilized flake | CAC-CCA-DL-919179 | Birbhanpur, West Bengal | Delhi |  |
| Blade | OT-EXB-DL-1035029 | Dholavira, Dist.- Kutch, Gujarat | Delhi |  |
| Blade | OT-EXB-DL-1064002 | Dholavira, Dist.- Kutch, Gujarat | Delhi |  |
| Blade | OT-EXB-DL-1063012 | Dholavira, Dist.- Kutch, Gujarat | Delhi |  |
| Shouldered arrow head | CAC-CCA-DL-1001247 | Cap-Blank | Delhi |  |
| Blade | CAC-CCA-DL-1001250 | Joera, Rajasthan | Delhi |  |
| Blade | OT-EXB-DL-1035133 | Dholavira, Dist.- Kutch, Gujarat | Delhi |  |
| Blade | OT-EXB-DL-1035191 | Dholavira, Dist.- Kutch, Gujarat | Delhi |  |
| Blade | OT-EXB-DL-1035231 | Dholavira, Dist.- Kutch, Gujarat | Delhi |  |
| Blade | OT-EXB-DL-1037495 | Dholavira, Dist.- Kutch, Gujarat | Delhi |  |
| Blade | OT-EXB-DL-1037511 | Dholavira, Dist.- Kutch, Gujarat | Delhi |  |
| Blade | OT-EXB-DL-1037543 | Dholavira, Dist.- Kutch, Gujarat | Delhi |  |
| Blade | OT-EXB-DL-1037701 | Dholavira, Dist.- Kutch, Gujarat | Delhi |  |
| Blade | OT-EXB-DL-1037710 | Dholavira, Dist.- Kutch, Gujarat | Delhi |  |
| Blade | OT-EXB-DL-1037722 | Dholavira, Dist.- Kutch, Gujarat | Delhi |  |
| Point | UM-MSU-GJ-364629 | Bagasra 03, Em 1, ④, 150 cm | Gujarat |  |
| Blade | OT-EXB-DL-1037735 | Dholavira, Dist.- Kutch, Gujarat | Delhi |  |
| Blade | OT-EXB-DL-1037738 | Dholavira, Dist.- Kutch, Gujarat | Delhi |  |
| Core | UM-DCP-MH-651261 | Mahurjhari MHR , District Nagpur, Maharashtra | Maharashtra |  |
| Blade | OT-EXB-DL-1037756 | Dholavira, Dist.- Kutch, Gujarat | Delhi |  |
| Drill Bit | GM-EXC-DL-761036 | Dholavira, Dist.- Kutch, Gujarat | Delhi |  |
| Blade | CAC-CCA-DL-940904 | Pachmarhi, Madhya Pradesh | Delhi |  |
| Blade | OT-EXB-DL-1037776 | Dholavira, Dist.- Kutch, Gujarat | Delhi |  |
| Point | CAC-CCA-DL-1015043 | karvan, Gujarat | Delhi |  |
| Blade | OT-EXB-DL-1037787 | Dholavira, Dist.- Kutch, Gujarat | Delhi |  |
| Blade | GM-EXC-DL-691965 | Dholavira, Dist.- Kutch, Gujarat | Delhi |  |
| Point | CAC-CCA-DL-891367 | Burzahom, Jammu & Kashmir | Delhi |  |
| Blade | OT-EXB-DL-1035546 | Dholavira, Dist.- Kutch, Gujarat | Delhi |  |
| Blade | OT-EXB-DL-1037794 | Dholavira, Dist.- Kutch, Gujarat | Delhi |  |
| Drill Bit | GM-EXC-DL-761064 | Dholavira, Dist.- Kutch, Gujarat | Delhi |  |
| Blade | OT-EXB-DL-1038138 | Dholavira, Dist.- Kutch, Gujarat | Delhi |  |
| Blade | OT-EXB-DL-1038139 | Dholavira, Dist.- Kutch, Gujarat | Delhi |  |
| Blade | OT-EXB-DL-1038140 | Dholavira, Dist.- Kutch, Gujarat | Delhi |  |
| Blade | OT-EXB-DL-1064605 | Dholavira, Dist.- Kutch, Gujarat | Delhi |  |
| Blade | OT-EXB-DL-1063043 | Dholavira, Dist.- Kutch, Gujarat | Delhi |  |
| Blade | OT-EXB-DL-1064012 | Dholavira, Dist.- Kutch, Gujarat | Delhi |  |
| Blade | OT-EXB-DL-1059206 | Dholavira, Dist.- Kutch, Gujarat | Delhi |  |
| Blade | OT-EXB-DL-1062916 | Dholavira, Dist.- Kutch, Gujarat | Delhi |  |
| Blade | OT-EXB-DL-1059201 | Dholavira, Dist.- Kutch, Gujarat | Delhi |  |
| Cleaver | UM-DCP-MH-785309 | NA | Maharashtra |  |
| Terpeze | GM-GJM-RJ-1001305 | Badmer | Rajasthan |  |
| Blade | OT-EXB-DL-1059219 | Dholavira, Dist.- Kutch, Gujarat | Delhi |  |
| Blade | OT-EXB-DL-1062943 | Dholavira, Dist.- Kutch, Gujarat | Delhi |  |
| Blade | OT-EXB-DL-1059226 | Dholavira, Dist.- Kutch, Gujarat | Delhi |  |
| Knife blade | CAC-CCA-DL-931561 | Sanur, Tamilnadu | Delhi |  |
| Blade | OT-EXB-DL-1061367 | Dholavira, Dist.- Kutch, Gujarat | Delhi |  |
| Blade | OT-EXB-DL-1059203 | Dholavira, Dist.- Kutch, Gujarat | Delhi |  |
| Blade | OT-EXB-DL-1059234 | Dholavira, Dist.- Kutch, Gujarat | Delhi |  |
| Blade | CAC-CCA-DL-915716 | Bahal ,Maharashtra | Delhi |  |
| Flake | CAC-CCA-DL-1001346 | Birbhanpur, West Bengal | Delhi |  |
| Blade | OT-EXB-DL-1059240 | Dholavira, Dist.- Kutch, Gujarat | Delhi |  |
| Drill Bit | GM-EXC-DL-750234 | Dholavira, Dist.- Kutch, Gujarat | Delhi |  |
| Blade | OT-EXB-DL-1038344 | Dholavira, Dist.- Kutch, Gujarat | Delhi |  |
| Flake | CAC-CCA-DL-1059788 | Birbhanpur, West Bengal | Delhi |  |
| Blade | OT-EXB-DL-1038346 | Dholavira, Dist.- Kutch, Gujarat | Delhi |  |
| Blade | CAC-CCA-DL-941232 | Chakradharpur, Jharkhand | Delhi |  |
| Blade | OT-EXB-DL-1038348 | Dholavira, Dist.- Kutch, Gujarat | Delhi |  |
| Flakes | UM-DCP-MH-551157 | Nevasa, District-Ahemadnagar, Maharashtra. | Maharashtra |  |
| Stone point | CAC-CCA-DL-931437 | Burzahom , Jammu & Kashmir | Delhi |  |
| Blade | CAC-CCA-DL-1001467 | Maski, Karnataka | Delhi |  |
| Flake Core | UM-DCP-MH-534614 | Gilund GLD , Dist. Rajsamand, Rajasthan | Maharashtra |  |
| Chips | UM-DCP-MH-567282 | Mahurjhari MHJ , District Nagpur, Maharashtra | Maharashtra |  |
| Blade | CAC-CCA-DL-941262 | Chakradharpur, Jharkhand | Delhi |  |
| Blade | CAC-CCA-DL-892781 | Pachmarhi, Madhya Pradesh | Delhi |  |
| Ball | SM-DAM-HR-388240 | Sugh, Yamunanagar | Haryana |  |
| Ball | SM-DAM-HR-388249 | Sugh, Yamunanagar | Haryana |  |
| Fragment of blade | CAC-CCA-DL-941382 | Pachmarhi ,Madhya Pradesh | Delhi |  |
| Blade | OT-EXB-DL-1038362 | Dholavira, Dist.- Kutch, Gujarat | Delhi |  |
| Blade | OT-EXB-DL-1038602 | Dholavira, Dist.- Kutch, Gujarat | Delhi |  |
| Blade | OT-EXB-DL-1038714 | Dholavira, Dist.- Kutch, Gujarat | Delhi |  |
| Blade | OT-EXB-DL-1038758 | Dholavira, Dist.- Kutch, Gujarat | Delhi |  |
| Flake Core | UM-DCP-MH-614680 | Bhimbetka, District-Raisen, Madhya Pradesh. | Maharashtra |  |
| Flakes | UM-DCP-MH-614823 | BGR-Bagor, Rajasthan. | Maharashtra |  |
| Flake Core | UM-DCP-MH-628464 | Bagor,Rajasthan BGR | Maharashtra |  |
| Flake Core | UM-DCP-MH-614089 | Bhimbetka, District-Raisen, Madhya Pradesh. | Maharashtra |  |
| Core | UM-DCP-MH-614399 | Bhimbetka, Madhya Pradesh, BTK | Maharashtra |  |
| Blade | OT-EXB-DL-1038770 | Dholavira, Dist.- Kutch, Gujarat | Delhi |  |
| Fragments of Hollow Point | CAC-CCA-DL-941537 | Nagda, Madhya Pradesh | Delhi |  |
| Blade | OT-EXB-DL-1040912 | Dholavira, Dist.- Kutch, Gujarat | Delhi |  |
| Blade | OT-EXB-DL-1041017 | Dholavira, Dist.- Kutch, Gujarat | Delhi |  |
| Core | UM-DCP-MH-579552 | Mahurjhari MHJ , District Nagpur, Maharashtra | Maharashtra |  |
| Blade | OT-EXB-DL-1059252 | Dholavira, Dist.- Kutch, Gujarat | Delhi |  |
| Blade | OT-EXB-DL-1061408 | Dholavira, Dist.- Kutch, Gujarat | Delhi |  |
| Borer cum scraper | CAC-CCA-DL-991216 | Japan | Delhi |  |
| Blade | OT-EXB-DL-1041094 | Dholavira, Dist.- Kutch, Gujarat | Delhi |  |
| Blade | OT-EXB-DL-1041095 | Dholavira, Dist.- Kutch, Gujarat | Delhi |  |
| Blade | OT-EXB-DL-1041097 | Dholavira, Dist.- Kutch, Gujarat | Delhi |  |
| Blade | OT-EXB-DL-1041870 | Dholavira, Dist.- Kutch, Gujarat | Delhi |  |
| Flake | CAC-CCA-DL-1059812 | Birbhanpur, West Bengal | Delhi |  |
| Blade | OT-EXB-DL-1041877 | Dholavira, Dist.- Kutch, Gujarat | Delhi |  |
| Blade | GM-EXC-DL-702684 | Dholavira, Dist.- Kutch, Gujarat | Delhi |  |
| Point | CAC-CCA-DL-1091200 | Burzohom, Jammu & Kashmir | Delhi |  |
| Flake | UM-DCP-MH-587418 | Patne PTN , District Jalgaon, Maharashtra | Maharashtra |  |
| Blade | OT-EXB-DL-1139694 | Dholavira, Dist.- Kutch, Gujarat | Delhi |  |
| Blade | OT-EXB-DL-1041882 | Dholavira, Dist.- Kutch, Gujarat | Delhi |  |
| Sling ball | GM-EXC-DL-692565 | Dholavira, Dist.- Kutch, Gujarat | Delhi |  |
| Blade | OT-EXB-DL-1059261 | Dholavira, Dist.- Kutch, Gujarat | Delhi |  |
| Blade | OT-EXB-DL-1059247 | Dholavira, Dist.- Kutch, Gujarat | Delhi |  |
| Blade | OT-EXB-DL-1059263 | Dholavira, Dist.- Kutch, Gujarat | Delhi |  |
| Blade | CAC-CCA-DL-1001394 | Maski, Karnataka | Delhi |  |
| Blade | CAC-CCA-DL-893030 | Bahal, Maharashtra | Delhi |  |
| Fragment of Bone point | CAC-CCA-DL-931213 | Burzahom, Jammu & Kashmir | Delhi |  |
| Blade | OT-EXB-DL-1064025 | Dholavira, Dist.- Kutch, Gujarat | Delhi |  |
| Blade | CAC-CCA-DL-1001422 | Maski, Karnataka | Delhi |  |
| Flake | UM-DCP-MH-487629 | Bhimbetka, District-Raisen, BTK-1973,Trench-IIIF23 Layer - 4. Locus- F2, E 3 F 4 | Maharashtra |  |
| Point | CAC-CCA-DL-984399 | Ujjain, Madhya Pradesh | Delhi |  |
| Blade | OT-EXB-DL-1059291 | Dholavira, Dist.- Kutch, Gujarat | Delhi |  |
| Blade | OT-EXB-DL-1064630 | Dholavira, Dist.- Kutch, Gujarat | Delhi |  |
| Point | CAC-CCA-DL-984369 | Ujjain, Madhya Pradesh | Delhi |  |
| Drill Bit | GM-EXC-DL-743457 | Dholavira, Dist.- Kutch, Gujarat | Delhi |  |
| Point | CAC-CCA-DL-984464 | Ujjain, Madhya Pradesh | Delhi |  |
| Point | CAC-CCA-DL-1001527 | Burzahom, Jammu & Kashmir | Delhi |  |
| Flake | CAC-CCA-DL-1001533 | Birbhanpur, West Bengal | Delhi |  |
| Flake | UM-DCP-MH-487696 | Bhimbetka, District-Raisen, BTK-1973,Trench-IIIF23 Layer - 4. Locus- J 2, F 2, F 4, J4 | Maharashtra |  |
| Plumb bob | OT-EXB-DL-1001610 | Mathura, Uttar Pradesh | Delhi |  |
| Blade | OT-EXB-DL-1064640 | Dholavira, Dist.- Kutch, Gujarat | Delhi |  |
| Arrow Head | GM-EXC-DL-755782 | Dholavira, Dist.- Kutch, Gujarat | Delhi |  |
| Blade | OT-EXB-DL-1042048 | Dholavira, Dist.- Kutch, Gujarat | Delhi |  |
| Drill Bit | GM-EXC-DL-761690 | Dholavira, Dist.- Kutch, Gujarat | Delhi |  |
| Blade | OT-EXB-DL-1042053 | Dholavira, Dist.- Kutch, Gujarat | Delhi |  |
| Blade | OT-EXB-DL-1042054 | Dholavira, Dist.- Kutch, Gujarat | Delhi |  |
| Blade | OT-EXB-DL-1042056 | Dholavira, Dist.- Kutch, Gujarat | Delhi |  |
| Chisel | CAC-CCA-DL-1041751 | Kaushambi, Uttar Pradesh | Delhi |  |
| Blade | OT-EXB-DL-1042058 | Dholavira, Dist.- Kutch, Gujarat | Delhi |  |
| Blade | OT-EXB-DL-1042062 | Dholavira, Dist.- Kutch, Gujarat | Delhi |  |
| Blade | OT-EXB-DL-1042064 | Dholavira, Dist.- Kutch, Gujarat | Delhi |  |
| Blade | OT-EXB-DL-1034123 | Dholavira, Dist.- Kutch, Gujarat | Delhi |  |
| Blade | CAC-CCA-DL-1001836 | Birbhanpur, West Bengal | Delhi |  |
| Small Ball | SM-AMG-HR-686621 | Sugh, Yamunanagar | Haryana |  |
| Blades | UM-DCP-MH-680422 | Bhimbetka, District-Raisen, Madhya Pradesh. | Maharashtra |  |
| Blade | OT-EXB-DL-1036063 | Dholavira, Dist.- Kutch, Gujarat | Delhi |  |
| Blades | UM-DCP-MH-680443 | Bhimbetka, District-Raisen, Madhya Pradesh. | Maharashtra |  |
| Blade | OT-EXB-DL-1038394 | Dholavira, Dist.- Kutch, Gujarat | Delhi |  |
| Blade | OT-EXB-DL-1042068 | Dholavira, Dist.- Kutch, Gujarat | Delhi |  |
| Flake | UM-MSU-GJ-421166 | Nagwada, NGW 88 XV A Layer ④ Depth 58cm | Gujarat |  |
| Handaxe | CAC-CCA-DL-918810 | Bilaspur, Himachal Pradesh | Delhi |  |
| Ball | SM-DAM-HR-404598 | Sugh, Yamunanagar | Haryana |  |
| Blade and Flakes | UM-DCP-MH-567450 | Bhimbetka, Dist. Raisen, Madhya Pradesh BTK | Maharashtra |  |
| Point | GM-EXC-DL-740635 | Dholavira, Dist.- Kutch, Gujarat | Delhi |  |
| Point | CAC-CCA-DL-1019543 | Burzahom, Jammu & Kashmir | Delhi |  |
| Blade | CAC-CCA-DL-1019594 | Sawyer puram, Tamilnadu | Delhi |  |
| Scraper | CAC-CCA-DL-1019631 | Sawyer puram, Tamilnadu | Delhi |  |
| Scraper | CAC-CCA-DL-1019640 | Sawyer puram, Tamilnadu | Delhi |  |
| Blade | OT-EXB-DL-1063237 | Dholavira, Dist.- Kutch, Gujarat | Delhi |  |
| Utilized flake | CAC-CCA-DL-939312 | Pachmarhi, Madhya Pradesh | Delhi |  |
| Core | CAC-CCA-DL-888891 | Joera, Rajasthan | Delhi |  |
| Blade | UM-MSU-GJ-420044 | Shikarpur,SKP-11 , Hc6 7 #9212 Layer ④ Depth 88 126 cm | Gujarat |  |
| Blade | UM-MSU-GJ-420059 | Shikarpur,SKP-11 , Hc6 7 #9212 Layer ④ Depth 88 126 cm | Gujarat |  |
| Scraper | CAC-CCA-DL-1019859 | Birbhanpur, West Bengal | Delhi |  |
| Chert Blade | SM-ZMH-HR-1031378 | Rakhigari | Haryana |  |
| Chert Blade | SM-ZMH-HR-1031223 | Rakhigari | Haryana |  |
| Chert Blade | SM-ZMH-HR-1031243 | Rakhigari | Haryana |  |
| Flake | CAC-CCA-DL-1020871 | Birbhanpur, West Bengal | Delhi |  |
| Chert Blade | SM-ZMH-HR-1031113 | Rakhigari | Haryana |  |
| Blade | OT-EXB-DL-1058911 | Dholavira, Dist.- Kutch, Gujarat | Delhi |  |
| Blade | GM-EXC-DL-738053 | Dholavira, Dist.- Kutch, Gujarat | Delhi |  |
| Blade | GM-EXC-DL-738176 | Dholavira, Dist.- Kutch, Gujarat | Delhi |  |
| Chert Blade | SM-ZMH-HR-1030899 | Rakhigari | Haryana |  |
| Chert Blade | SM-ZMH-HR-1030909 | Rakhigari | Haryana |  |
| Chert Blade | SM-ZMH-HR-1030933 | Rakhigari | Haryana |  |
| Chert Blade | SM-ZMH-HR-1030714 | Rakhigari | Haryana |  |
| Chert Blade | SM-ZMH-HR-1030517 | Rakhigari | Haryana |  |
| Blade | CAC-CCA-DL-893397 | Bahal, Maharashtra | Delhi | A.jpg) |
| Flake | CAC-CCA-DL-888935 | Pachmarhi, Madhya Pradesh | Delhi |  |
| Flake | UM-MSU-GJ-422502 | Nagwada, NGW 89 XXX A Layer ④ Depth 39cm | Gujarat |  |
| Flake | UM-MSU-GJ-422802 | Nagwada, NGW 87 IX A Bauk of Pit - 4 Depth 25cm | Gujarat | .jpg) |
| Celt | NM-ALH-UP-131156 | N A | Uttar Pradesh |  |
| Blade | OT-EXB-DL-1059725 | Dholavira, Dist.- Kutch, Gujarat | Delhi |  |
| Blade | OT-EXB-DL-1059069 | Dholavira, Dist.- Kutch, Gujarat | Delhi |  |
| Point | CAC-CCA-DL-1002694 | Burzahom, Jammu & Kashmir | Delhi |  |
| Point | CAC-CCA-DL-1020603 | Birbhanpur, West Bengal | Delhi |  |
| Blade | CAC-CCA-DL-1020619 | Birbhanpur, West Bengal | Delhi |  |
| Core | CAC-CCA-DL-1020632 | Birbhanpur, West Bengal | Delhi |  |
| Blade | CAC-CCA-DL-893425 | Bahal, Maharashtra | Delhi | A.jpg) |
| Flake | CAC-CCA-DL-1020650 | Birbhanpur, West Bengal | Delhi |  |
| Chips | UM-DCP-MH-676061 | Mahurjhari MHJ , District Nagpur, Maharashtra | Maharashtra |  |
| Fragment of blade | CAC-CCA-DL-1041282 | Bahal, Maharashtra | Delhi |  |
| Blade | CAC-CCA-DL-1041299 | Bahal, Maharashtra | Delhi |  |
| Ball | CAC-CCA-DL-1129116 | Nagda, Madhya Pradesh | Delhi |  |
| Blade | OT-EXB-DL-1038330 | Dholavira, Dist.- Kutch, Gujarat | Delhi |  |
| Core | UM-DCP-MH-530405 | Bagor, Dist. Bilwara,Rajasthan, BGR . | Maharashtra |  |
| Blade Pieces | SM-DAM-HR-331328 | Kunal, Fatehabad | Haryana |  |
| Ball | CAC-CCA-DL-1128510 | Nagda, Madhya Pradesh | Delhi |  |
| Sling ball | GM-EXC-DL-687862 | Dholavira, Dist.- Kutch, Gujarat | Delhi |  |
| Ball | GM-EXC-DL-704117 | Dholavira, Dist.- Kutch, Gujarat | Delhi |  |
| Chisel | CAC-CCA-DL-1114122 | Chanh daro , Pakistan | Delhi |  N1.jpg) |
| Flake Chips | UM-DCP-MH-423099 | Bagor, Rajasthan, BGR E IV - V | Maharashtra |  |
| Blade | CAC-CCA-DL-911168 | Birbhanpur, West Bengal | Delhi |  |
| Blade | CAC-CCA-DL-911171 | Birbhanpur, West Bengal | Delhi |  |
| Flake | UM-DCP-MH-488117 | Bhimbetka, District-Raisen, BTK-1973,Trench-IIIF23 Layer - 4. Locus- E3.F3.G3 | Maharashtra |  |
| Dabber | GM-MAG-RJ-818586 | Rairh Tonk | Rajasthan |  |
| Flake | CAC-CCA-DL-1059741 | Birbhanpur, West Bengal | Delhi |  |
| Hook | GM-EXC-DL-749037 | Dholavira, Dist.- Kutch, Gujarat | Delhi |  |
| Blade | UM-MSU-GJ-358040 | Bagasra, BSR-04 Ei11 Layer② Depth 40cms | Gujarat |  |
| Core | CAC-CCA-DL-1042046 | Joera, Rajasthan | Delhi |  |
| Blade | OT-EXB-DL-1059968 | Dholavira, Dist.- Kutch, Gujarat | Delhi |  |
| Blade | CAC-CCA-DL-911784 | Birbhanpur, West Bengal | Delhi |  |
| Blade | OT-EXB-DL-1060172 | Dholavira, Dist.- Kutch, Gujarat | Delhi |  |
| Blade | GM-EXC-DL-737683 | Dholavira, Dist.- Kutch, Gujarat | Delhi |  |
| Blade | GM-EXC-DL-736156 | Dholavira, Dist.- Kutch, Gujarat | Delhi |  |
| Flake Chips | UM-DCP-MH-423234 | Bagor, Rajasthan, BGR E IV - V | Maharashtra |  |
| Flake Chips | UM-DCP-MH-423441 | Bagor, Rajasthan, BGR E IV - V | Maharashtra |  |
| Blade | OT-EXB-DL-1062102 | Dholavira, Dist.- Kutch, Gujarat | Delhi |  |
| Blade | GM-EXC-DL-726252 | Dholavira, Dist.- Kutch, Gujarat | Delhi |  |
| Pebble | CAC-CCA-DL-920367 | Bahadrabad, Uttarakhand | Delhi |  |
| Blade | UM-DCP-MH-423741 | Bagor, Rajasthan, BGR, FV-5,L 150,1969-70 | Maharashtra |  |
| Flake | CAC-CCA-DL-1042120 | Bahal, Maharashtra | Delhi |  |
| Point | CAC-CCA-DL-1056069 | Burzahom, Jammu & Kashmir | Delhi |  |
| Blade | CAC-CCA-DL-1058259 | Bahal, Maharashtra | Delhi |  |
| Blade | UM-DCP-MH-423766 | Bagor, Rajasthan, BGR, FV-5,L 150,1969-70 | Maharashtra |  |
| Flake Core | UM-DCP-MH-481037 | Bhimbetka, Madhya Pradesh, BTK | Maharashtra |  |
| Blade | CAC-CCA-DL-1042157 | Bahal, Maharashtra | Delhi |  |
| Flake Chips | UM-DCP-MH-423882 | Bagor, Rajasthan, BGR E IV - V | Maharashtra |  |
| Rubber Stone | UM-DCP-MH-423887 | Kuntasi, Tehsil - Maliya, Dist - Rajkot, Trench - F 10 ,Locus - SE Layer - 6 | Maharashtra |  |
| Side scraper | CAC-CCA-DL-1060393 | Birbhanpur, West Bengal | Delhi |  |
| Blade | OT-EXB-DL-1064193 | Dholavira, Dist.- Kutch, Gujarat | Delhi |  |
| Blades | UM-DCP-MH-424094 | Bagor, Rajasthan, BGR G III - 15 99 - 108 26 BGR G III - 13 99 - 108 129 | Maharashtra |  |
| Flake Chips | UM-DCP-MH-424108 | Bagor, Rajasthan, BGR E IV - V | Maharashtra |  |
| Blade | UM-DCP-MH-424175 | Bagor, Rajasthan, BGR, FV-5,L 150,1969-70 | Maharashtra |  |
| Blade | UM-DCP-MH-424226 | Bagor, Rajasthan, BGR F III - 4 | Maharashtra |  |
| Flake Chips | UM-DCP-MH-424252 | Bagor, Rajasthan, BGR E IV - V | Maharashtra |  |
| Blades | UM-DCP-MH-424246 | Bagor, Rajasthan, BGR G III - 7 99 - 108 128 | Maharashtra |  |
| Blade | UM-DCP-MH-424303 | Bagor, Rajasthan, BGR F III - 4 | Maharashtra |  |
| Point | CAC-CCA-DL-1054835 | Burzahom, Jammu & Kashmir | Delhi |  |
| Point | CAC-CCA-DL-1054916 | Burzahom, Jammu & Kashmir | Delhi |  |
| Utilised Flake | UM-MSU-GJ-363558 | Datrana | Gujarat |  |
| Drill Bit | OT-EXB-DL-1206534 | Dholavira, Dist.- Kutch, Gujarat | Delhi |  |
| Blades | UM-DCP-MH-424431 | Inamgaon, Maharashtra | Maharashtra |  |
| Scrubber | SM-DAM-HR-405238 | Sugh, Yamunanagar | Haryana |  |
| Ball | SM-DAM-HR-405255 | Sugh, Yamunanagar | Haryana |  |
| Ball | SM-DAM-HR-405214 | Sugh, Yamunanagar | Haryana |  |
| Ball | SM-DAM-HR-405225 | Sugh, Yamunanagar | Haryana |  |
| Ball | SM-DAM-HR-405230 | Sugh, Yamunanagar | Haryana |  |
| Ball | SM-DAM-HR-404842 | Sugh, Yamunanagar | Haryana |  |
| Blade | GM-EXC-DL-721715 | Dholavira, Dist.- Kutch, Gujarat | Delhi |  |
| Quern | UM-DCP-MH-424504 | Kuntasi, Tehsil - Maliya, Dist - Rajkot, Trench - E 12 , Layer - 1 | Maharashtra |  |
| Blade | CAC-CCA-DL-919169 | Birbhanpur, West Bengal | Delhi |  |
| Flake | CAC-CCA-DL-938386 | Pachmarhi, Madhya Pradesh | Delhi |  |
| Microlith | UM-DCP-MH-673872 | Bhimbhetka BTK , District Raisen Madhya Pradesh | Maharashtra |  |
| Chert Blade | SM-ZMH-HR-1023242 | Rakhigari | Haryana |  |
| Utilized Flake | CAC-CCA-DL-1060443 | Birbhanpur, West Bengal | Delhi |  |
| Point | CAC-CCA-DL-892628 | Burzahom, Jammu & Kashmir | Delhi |  |
| Core | UM-DCP-MH-664528 | Bagor BGR , Tehsil Mandal, District Bhilwara, Rajasthan | Maharashtra |  |
| Blade | OT-EXB-DL-1040184 | Dholavira, Dist.- Kutch, Gujarat | Delhi |  |
| Bone point | CAC-CCA-DL-1026949 | Burzahom, Jammu & Kashmir | Delhi |  |
| Core | UM-DCP-MH-614228 | Bagor BGR , Tehsil Mandal, District Bhilwara, Rajasthan | Maharashtra |  |
| Point | CAC-CCA-DL-1053785 | Burzahom, Jammu & Kashmir | Delhi |  |
| Blade | OT-EXB-DL-1045440 | Dholavira, Dist.- Kutch, Gujarat | Delhi |  |
| Flake | CAC-CCA-DL-1060398 | Birbhanpur, West Bengal | Delhi |  |
| Fragment of Iron spearhead | OT-KPJ-BR-1218100 | Panr | Bihar |  |
| Point | CAC-CCA-DL-1053908 | Burzahom, Jammu & Kashmir | Delhi |  |
| Point | CAC-CCA-DL-1053929 | Burzahom, Jammu & Kashmir | Delhi |  |
| Point | CAC-CCA-DL-1054036 | Burzahom, Jammu & Kashmir | Delhi |  |
| Point | CAC-CCA-DL-1054089 | Burzahom, Jammu & Kashmir | Delhi |  |
| Point | CAC-CCA-DL-1054121 | Burzahom, Jammu & Kashmir | Delhi |  |
| Flakes | UM-DCP-MH-679003 | Bhimbetka, District-Raisen, Madhya Pradesh. | Maharashtra |  |
| Handaxe | CAC-CCA-DL-918894 | Bilaspur, Himachal Pradesh | Delhi |  |
| Flake | CAC-CCA-DL-918958 | Birbhanpur, West Bengal | Delhi |  |
| Core | UM-DCP-MH-475270 | Gilund, District Rajsamand, Rajasthan, GLD Trench 5270017, Layer 25, 1999-2005 | Maharashtra |  |
| Sling ball | GM-EXC-DL-689473 | Dholavira, Dist.- Kutch, Gujarat | Delhi |  |
| Blade | OT-EXB-DL-1046293 | Dholavira, Dist.- Kutch, Gujarat | Delhi |  |
| Drill Bit | GM-EXC-DL-749041 | Dholavira, Dist.- Kutch, Gujarat | Delhi |  |
| Point | CAC-CCA-DL-920478 | Burzahom, Jammu & Kashmir | Delhi |  |
| Core | UM-DCP-MH-439661 | QuartBagor, Rajasthan | Maharashtra |  |
| Microlith | UM-DCP-MH-674978 | Bhimbhetka BTK , District Raisen Madhya Pradesh | Maharashtra |  |
| Blade | OT-EXB-DL-1046314 | Dholavira, Dist.- Kutch, Gujarat | Delhi |  |
| Blade | OT-EXB-DL-1046315 | Dholavira, Dist.- Kutch, Gujarat | Delhi |  |
| Flakes | UM-DCP-MH-544880 | Pipla-1 | Maharashtra |  |
| Blade | OT-EXB-DL-1046316 | Dholavira, Dist.- Kutch, Gujarat | Delhi |  |
| Blade | CAC-CCA-DL-920436 | Birbhanpur, West Bangal | Delhi |  |
| flake | CAC-CCA-DL-920439 | Bahadrabad, Uttarakhand | Delhi |  |
| Scraper | CAC-CCA-DL-890076 | Joera, Rajasthan | Delhi |  |
| Scraper | CAC-CCA-DL-890302 | Joera, Rajasthan | Delhi |  |
| Microlith | UM-DCP-MH-675098 | Bhimbhetka BTK , District Raisen Madhya Pradesh | Maharashtra |  |
| Core | UM-DCP-MH-675105 | Bhimbhetka BTK , District Raisen Madhya Pradesh | Maharashtra |  |
| Flake Core | UM-DCP-MH-675088 | Bhimbetka, Madhya Pradesh, BTK | Maharashtra |  |
| Flake | CAC-CCA-DL-890806 | Pachmarhi, Madhya Pradesh | Delhi |  |
| Blade | OT-EXB-DL-1038145 | Dholavira, Dist.- Kutch, Gujarat | Delhi |  |
| Blade | OT-EXB-DL-1038146 | Dholavira, Dist.- Kutch, Gujarat | Delhi |  |
| Flake | CAC-CCA-DL-1002926 | Birbhanpur, West Bengal | Delhi |  |
| Needle | CAC-CCA-DL-1105758 | Burzahom, Jammu & Kashmir | Delhi |  |
| Blade | CAC-CCA-DL-939389 | Birbhanpur, West Bengal | Delhi |  |
| Flake | UM-DCP-MH-488210 | Bhimbetka, District-Raisen, BTK-1973,Trench-IIIF23 Layer - 4. Locus- F2.E3.G2 | Maharashtra |  |
| Flake | UM-DCP-MH-488254 | Bhimbetka, District-Raisen, BTK-1973,Trench-IIIF23 Layer - 4. Locus- E3.F3.G3.J4 | Maharashtra |  |
| Blade | OT-EXB-DL-1050373 | Dholavira, Dist.- Kutch, Gujarat | Delhi |  |
| Blade | OT-EXB-DL-1050819 | Dholavira, Dist.- Kutch, Gujarat | Delhi |  |
| Blade | OT-EXB-DL-1050820 | Dholavira, Dist.- Kutch, Gujarat | Delhi |  |
| Flakes | UM-DCP-MH-543737 | NLY-Nelyo 10 02 1978 | Maharashtra |  |
| Point | CAC-CCA-DL-955506 | Burzahom, Jammu & Kashmir | Delhi |  |
| Flake Core | UM-DCP-MH-675416 | Bhimbetka, Madhya Pradesh, BTK | Maharashtra |  |
| Microlith | UM-DCP-MH-675410 | Bhimbhetka BTK , District Raisen Madhya Pradesh | Maharashtra |  |
| Core | UM-DCP-MH-675411 | Bhimbetka, Madhya Pradesh, BTK | Maharashtra |  |
| Microlith | UM-DCP-MH-675427 | Bhimbhetka BTK , District Raisen Madhya Pradesh | Maharashtra |  |
| Blade | OT-EXB-DL-1050816 | Dholavira, Dist.- Kutch, Gujarat | Delhi |  |
| Blade | OT-EXB-DL-1050452 | Dholavira, Dist.- Kutch, Gujarat | Delhi |  |
| Blade | UM-DCP-MH-675480 | Bagor, District Dilwara, Rajasthan,Tr - , Depth- | Maharashtra |  |
| Core | UM-DCP-MH-675497 | Bhimbhetka BTK , District Raisen Madhya Pradesh | Maharashtra |  |
| Microlith | UM-DCP-MH-675486 | Bhimbhetka BTK , District Raisen Madhya Pradesh | Maharashtra |  |
| Blade | CAC-CCA-DL-911838 | Garakwali, Pakistan | Delhi |  |
| Blade | UM-DCP-MH-675509 | Bagor, District Dilwara, Rajasthan,Tr - , Depth- | Maharashtra |  |
| Flake Core | UM-DCP-MH-486400 | Gilund, Rajasthan | Maharashtra |  |
| Flake | UM-DCP-MH-653631 | Balathal, Rajasthan BTL , 1998-99 | Maharashtra |  |
| Flake | UM-DCP-MH-653951 | Balathal, Rajasthan BTL , 1998-99 | Maharashtra |  |
| Flakes | UM-DCP-MH-675600 | Bhimbetka, District-Raisen, Madhya Pradesh. | Maharashtra |  |
| Point | CAC-CCA-DL-955908 | Burzahom, Jammu & Kashmir | Delhi |  |
| Flake Core | UM-DCP-MH-486705 | Gilund, Rajasthan | Maharashtra |  |
| Flake | UM-DCP-MH-654531 | Balathal, Rajasthan BTL , 1998-99 | Maharashtra |  |
| Flake | UM-DCP-MH-654563 | Balathal, Rajasthan BTL , 1998-99 | Maharashtra |  |
| Flake | UM-DCP-MH-675743 | Vodikalu VDL , Andhra Pradesh | Maharashtra |  |
| Flake | UM-DCP-MH-488381 | Bhimbetka, District-Raisen, BTK-1973,Trench-IIIF23 Layer - 4. Locus- K3.F2.E3.G3 | Maharashtra |  |
| Flake | UM-DCP-MH-488428 | Bhimbetka, District-Raisen, BTK-1973,Trench-IIIF23 Layer - 4. Locus- G3.E3.H4 | Maharashtra |  |
| Flake | UM-DCP-MH-488448 | Bhimbetka, District-Raisen, BTK-1973,Trench-IIIF23 Layer - 4. Locus- E3.F2.H3 | Maharashtra |  |
| Core | UM-DCP-MH-675840 | Bhimbhetka BTK , District Raisen Madhya Pradesh | Maharashtra |  |
| Rod | GM-EXC-DL-731757 | Dholavira, Dist.- Kutch, Gujarat | Delhi |  |
| Flake | UM-DCP-MH-650116 | Balathal, Rajasthan BTL , 1998-99 | Maharashtra |  |
| Flake Core | UM-DCP-MH-486756 | Gilund, Rajasthan | Maharashtra |  |
| Blade | GM-EXC-DL-731770 | Dholavira, Dist.- Kutch, Gujarat | Delhi |  |
| Flake Core | UM-DCP-MH-486945 | Gilund, Rajasthan | Maharashtra |  |
| Burin | CAC-CCA-DL-913695 | Nagda, Madhya Pradesh | Delhi |  |
| Blade | CAC-CCA-DL-911845 | Bikaner, Rajasthan | Delhi |  |
| Flake Core | UM-DCP-MH-486105 | Gilund, Rajasthan | Maharashtra |  |
| Flake | UM-DCP-MH-652278 | Balathal, Rajasthan BTL , 1998-99 | Maharashtra |  |
| Flake | UM-DCP-MH-652402 | Balathal, Rajasthan BTL , 1998-99 | Maharashtra |  |
| Flake Core | UM-DCP-MH-485988 | Gilund, Rajasthan | Maharashtra |  |
| Flake Core | UM-DCP-MH-486036 | Gilund, Rajasthan | Maharashtra |  |
| Flake Core | UM-DCP-MH-486061 | Gilund, Rajasthan | Maharashtra |  |
| Flake Core | UM-DCP-MH-484314 | Gilund, Rajasthan | Maharashtra |  |
| Flake Core | UM-DCP-MH-484487 | Gilund, Rajasthan | Maharashtra |  |
| Flake Core | UM-DCP-MH-485037 | Gilund, Rajasthan | Maharashtra |  |
| Flake Core | UM-DCP-MH-485057 | Gilund, Rajasthan | Maharashtra |  |
| Flake Core | UM-DCP-MH-485709 | Gilund, Rajasthan | Maharashtra |  |
| Blade | GM-EXC-DL-731769 | Dholavira, Dist.- Kutch, Gujarat | Delhi |  |
| Blade | OT-EXB-DL-1050924 | Dholavira, Dist.- Kutch, Gujarat | Delhi |  |
| Point | CAC-CCA-DL-956794 | Burzahom, Jammu & Kashmir | Delhi |  |
| Blade | UM-DCP-MH-675603 | Bhimbetka, District-Raisen, Madhya Pradesh. | Maharashtra |  |
| Flake Core | UM-DCP-MH-675919 | Bhimbetka, Dist. Raisen, Madhya Pradesh BTK | Maharashtra |  |
| Flake Core | UM-DCP-MH-484101 | Gilund, Rajasthan | Maharashtra |  |
| Handaxe | CAC-CCA-DL-911857 | Daimabad, Maharashtra | Delhi |  |
| Flake Core | UM-DCP-MH-483228 | Gilund, Rajasthan | Maharashtra |  |
| Flake Core | UM-DCP-MH-483485 | Gilund, Rajasthan | Maharashtra |  |
| Flake Core | UM-DCP-MH-483624 | Gilund, Rajasthan | Maharashtra |  |
| Hammer Stone | UM-DCP-MH-678218 | Kuntasi, KTS . Dist.Rajkot, Gujarat. | Maharashtra |  |
| Flake Core | UM-DCP-MH-477913 | Gilund, Rajasthan | Maharashtra |  |
| Flake Core | UM-DCP-MH-478615 | Gilund, Rajasthan | Maharashtra |  |
| Flake Core | UM-DCP-MH-478531 | Gilund, Rajasthan | Maharashtra |  |
| Flake Core | UM-DCP-MH-483150 | Gilund, Rajasthan | Maharashtra |  |
| Flake core | UM-DCP-MH-482780 | Bagor, Rajasthan, BGR E,F,G, 1968-69 | Maharashtra |  |
| Blade | CAC-CCA-DL-1017089 | Birbhanpur, West Bengal | Delhi |  |
| Flake | CAC-CCA-DL-1017098 | Birbhanpur, West Bengal | Delhi |  |
| Flake | UM-DCP-MH-488584 | Bhimbetka, District-Raisen, BTK-1973,Trench-IIIF23 Layer - 4. Locus- G3.F2.J7 | Maharashtra |  |
| Flake | UM-DCP-MH-488606 | Bhimbetka, District-Raisen, BTK-1973,Trench-IIIF23 Layer - 4. Locus- F4.G2.H4.J7 | Maharashtra |  |
| Blade | OT-EXB-DL-1047266 | Dholavira, Dist.- Kutch, Gujarat | Delhi |  |
| Blade | OT-EXB-DL-1050920 | Dholavira, Dist.- Kutch, Gujarat | Delhi |  |
| Blade | OT-EXB-DL-1050921 | Dholavira, Dist.- Kutch, Gujarat | Delhi |  |
| Point | CAC-CCA-DL-955719 | Burzahom, Jammu & Kashmir | Delhi |  |
| Blade | CAC-CCA-DL-1017109 | Harappa, Pakistan | Delhi |  |
| Flake | UM-DCP-MH-648824 | Balathal, Rajasthan BTL , 1998-99 | Maharashtra |  |
| Flake | UM-DCP-MH-648850 | Balathal, Rajasthan BTL , 1998-99 | Maharashtra |  |
| Flake | UM-DCP-MH-649051 | Balathal, Rajasthan BTL , 1998-99 | Maharashtra |  |
| Blade | GM-EXC-DL-731792 | Dholavira, Dist.- Kutch, Gujarat | Delhi |  |
| Flake core | UM-DCP-MH-480941 | Bagor, Rajasthan, BGR E,F,G, 1968-69 | Maharashtra |  |
| Flake core | UM-DCP-MH-481241 | Bagor, Rajasthan, BGR E,F,G, 1968-69 | Maharashtra |  |
| Flake | UM-DCP-MH-649228 | Balathal, Rajasthan BTL , 1998-99 | Maharashtra |  |
| Flake | UM-DCP-MH-649266 | Balathal, Rajasthan BTL , 1998-99 | Maharashtra |  |
| Flake | UM-DCP-MH-649514 | Balathal, Rajasthan BTL , 1998-99 | Maharashtra |  |
| Sling Ball | GM-EXC-DL-731788 | Dholavira, Dist.- Kutch, Gujarat | Delhi |  |
| Flake core | UM-DCP-MH-480036 | Bagor, Rajasthan, BGR E,F,G, 1968-69 | Maharashtra |  |
| Flake core | UM-DCP-MH-480056 | Bagor, Rajasthan, BGR E,F,G, 1968-69 | Maharashtra |  |
| Flake core | UM-DCP-MH-479843 | Bagor, Rajasthan, BGR E,F,G, 1968-69 | Maharashtra |  |
| Flake core | UM-DCP-MH-481926 | Bagor, Rajasthan, BGR E,F,G, 1968-69 | Maharashtra |  |
| Flake Core | UM-DCP-MH-676157 | Bhimbetka, Dist. Raisen, Madhya Pradesh BTK | Maharashtra |  |
| Microlith | UM-DCP-MH-676163 | Bhimbhetka BTK , District Raisen Madhya Pradesh | Maharashtra |  |
| Flake Core | UM-DCP-MH-676151 | Hunsgi, Dist.Gulbarga, Karnataka | Maharashtra |  |
| Flake Core | UM-DCP-MH-479114 | Gilund, Rajasthan | Maharashtra |  |
| Flake Core | UM-DCP-MH-478930 | Gilund, Rajasthan | Maharashtra |  |
| Flake Core | UM-DCP-MH-479286 | Gilund, Rajasthan | Maharashtra |  |
| Flake | UM-DCP-MH-676268 | Vodikalu VDL , Andhra Pradesh | Maharashtra |  |
| Flake Core | UM-DCP-MH-676274 | Bhimbetka, Dist. Raisen, Madhya Pradesh BTK | Maharashtra |  |
| Flake | UM-DCP-MH-794872 | SPG | Maharashtra |  |
| Flake | CAC-CCA-DL-921537 | Birbhanpur, West Bangal | Delhi |  |
| Blade | OT-EXB-DL-1064673 | Dholavira, Dist.- Kutch, Gujarat | Delhi |  |
| Scraper | CAC-CCA-DL-1017191 | Birbhanpur, West Bengal | Delhi |  |
| Scraper | CAC-CCA-DL-1017244 | Birbhanpur, West Bengal | Delhi |  |
| Muller | CAC-CCA-DL-1017266 | Bhorgarh | Delhi |  |
| Flake core | UM-DCP-MH-480077 | Bagor, Rajasthan, BGR E,F,G, 1968-69 | Maharashtra |  |
| Flake core | UM-DCP-MH-480095 | Bagor, Rajasthan, BGR E,F,G, 1968-69 | Maharashtra |  |
| Flake Core | UM-DCP-MH-479275 | Gilund, Rajasthan | Maharashtra |  |
| Blade | CAC-CCA-DL-914800 | Bahal ,Maharashtra | Delhi |  A.jpg) |
| Flake Core | UM-DCP-MH-479305 | Gilund, Rajasthan | Maharashtra |  |
| Microlith | UM-DCP-MH-676776 | Bhimbhetka BTK , District Raisen Madhya Pradesh | Maharashtra |  |
| Blade | OT-EXB-DL-1059560 | Dholavira, Dist.- Kutch, Gujarat | Delhi |  |
| Blade | OT-EXB-DL-1064681 | Dholavira, Dist.- Kutch, Gujarat | Delhi |  |
| Blade | CAC-CCA-DL-1017494 | Birbhanpur, West Bengal | Delhi |  |
| Blade | OT-EXB-DL-1062999 | Dholavira, Dist.- Kutch, Gujarat | Delhi |  |
| Blade | OT-EXB-DL-1061631 | Dholavira, Dist.- Kutch, Gujarat | Delhi |  |
| Nail | GM-EXC-DL-739922 | Dholavira, Dist.- Kutch, Gujarat | Delhi |  |
| Blade and Flakes | UM-DCP-MH-567696 | Bhimbetka, Dist. Raisen, Madhya Pradesh BTK | Maharashtra |  |
| Scraper | CAC-CCA-DL-1060341 | Attirampakkam, Tamilnadu | Delhi |  |
| Sling Ball | GM-EXC-DL-739911 | Dholavira, Dist.- Kutch, Gujarat | Delhi |  |
| Drill Bit | GM-EXC-DL-739931 | Dholavira, Dist.- Kutch, Gujarat | Delhi |  |
| Microlith | UM-DCP-MH-676904 | Bhimbhetka BTK , District Raisen Madhya Pradesh | Maharashtra |  |
| Rod | GM-EXC-DL-739943 | Dholavira, Dist.- Kutch, Gujarat | Delhi |  |
| Blade | CAC-CCA-DL-918486 | Kuchhai, Orissa | Delhi |  |
| Scraper | CAC-CCA-DL-918525 | Birbhanpur, West Bengal | Delhi |  |
| Point | CAC-CCA-DL-913223 | Burzahom, Jammu & Kashmir | Delhi |  |
| Microlith | UM-DCP-MH-677058 | Bhimbhetka BTK , District Raisen Madhya Pradesh | Maharashtra |  |
| Sling Ball | GM-EXC-DL-727138 | Dholavira, Dist.- Kutch, Gujarat | Delhi |  |
| Fragment of harpoon | CAC-CCA-DL-1002454 | Burzahom, Jammu & Kashmir | Delhi |  |
| Flake Core | UM-DCP-MH-677323 | Bhimbetka,Dist.Raisen, Madhya Pradesh, BTK | Maharashtra |  |
| Flakes | UM-DCP-MH-597206 | VDCH-5 Renigunta | Maharashtra |  |
| Point | CAC-CCA-DL-1002548 | Burzahom, Jammu & Kashmir | Delhi |  |
| Core | UM-DCP-MH-678165 | Bhimbetka, Madhya Pradesh, BTK | Maharashtra |  |
| Core | UM-DCP-MH-678154 | Bhimbhetka BTK , District Raisen Madhya Pradesh | Maharashtra |  |
| Core | UM-DCP-MH-678286 | Bhimbhetka BTK , District Raisen Madhya Pradesh | Maharashtra |  |
| Raw Material | SM-DAM-HR-373810 | Banawali, Fatehabad | Haryana |  |
| Blade | CAC-CCA-DL-980055 | Maski, Karnataka | Delhi |  |
| Flake | CAC-CCA-DL-941887 | Pachmarhi ,Madhya Pradesh | Delhi |  |
| Flake | CAC-CCA-DL-915496 | Birbhanpur, West Bengal | Delhi |  |
| Blade | GM-EXC-DL-727729 | Dholavira, Dist.- Kutch, Gujarat | Delhi |  |
| Sling Ball | GM-EXC-DL-727745 | Dholavira, Dist.- Kutch, Gujarat | Delhi |  |
| Chisel | GM-EXC-DL-727750 | Dholavira, Dist.- Kutch, Gujarat | Delhi |  |
| Flake | CAC-CCA-DL-1018791 | Birbhanpur, West Bengal | Delhi |  |
| Sling Ball | GM-EXC-DL-752061 | Dholavira, Dist.- Kutch, Gujarat | Delhi |  |
| Core | UM-DCP-MH-487113 | Patne, Disrict Jalgaon, Maharashtra. | Maharashtra |  |
| Core | UM-DCP-MH-487387 | Patne, Disrict Jalgaon, Maharashtra. | Maharashtra |  |
| Flakes | UM-DCP-MH-481657 | Bhimbetka, Madhya Pradesh. | Maharashtra |  |
| Flakes | UM-DCP-MH-481969 | Bhimbetka, Madhya Pradesh. | Maharashtra |  |
| Crescent | PM-PCO-OR-1354110 | Mahabinayak, Chandikhol, Jajpur | Orissa |  |
| Flake | UM-DCP-MH-467702 | Gilund, District Rajsamand, Rajasthan, GLD Trench 5270017, Layer25, 1999-2005 | Maharashtra |  |
| Flake | UM-DCP-MH-489113 | Bhimbetka, District-Raisen, BTK-1973,Trench-IIIF23 Layer - 4. Locus- E1.K2. | Maharashtra |  |
| Blade | GM-EXC-DL-734133 | Dholavira, Dist.- Kutch, Gujarat | Delhi |  |
| Worked Bone | UM-DCP-MH-464043 | Balathal 1996-97, Tehsil - Vallabhnagar, District - Udaipur, Rajasthan, Trench -A2 ,Depth 2.10 mtr ,Locus NE # 8129 Lot No 10032 Layer 13 | Maharashtra |  |
| ball | GM-MAG-RJ-806943 | Unknown | Rajasthan |  |
| Core | CAC-CCA-DL-1231067 | Prakash, Maharashtra | Delhi |  |
| Arrow head | OT-KPJ-BR-1218214 | Panr | Bihar |  |
| Drill Bit | GM-EXC-DL-738920 | Dholavira, Dist.- Kutch, Gujarat | Delhi |  |
| Flake | CAC-CCA-DL-916934 | Afyeh nubia. Egypt | Delhi |  |
| Chert Blade | SM-DAM-HR-369808 | Banawali, Fatehabad | Haryana |  |
| Detached flake | PM-PCO-OR-1353264 | Taila,Karadapal, Sukinda, Jajpur. | Orissa |  |
| Chert Blade | SM-DAM-HR-369443 | Banawali, Fatehabad | Haryana |  |
| Flake | UM-DCP-MH-489996 | Bhimbetka, District-Raisen, BTK-1973,Trench-IIIF23 Layer - 4. Locus- K5.F2 | Maharashtra |  |
| Flake | UM-DCP-MH-490016 | Bhimbetka, District-Raisen, BTK-1973,Trench-IIIF23 Layer - 4. Locus- H3.E3.G1.F4 | Maharashtra |  |
| Flake | UM-DCP-MH-490038 | Bhimbetka, District-Raisen, BTK-1973,Trench-IIIF23 Layer - 4. Locus- L8.E4.E3 | Maharashtra |  |
| Chert Blade | SM-DAM-HR-369761 | Banawali, Fatehabad | Haryana |  |
| Sandstone Muller | GM-DAI-UP-1137495 | Charda Bahraich | Uttar Pradesh |  |
| Sandstone Muller | GM-DAI-UP-1137508 | Charda Bahraich | Uttar Pradesh |  |
| Chert Blade | SM-DAM-HR-369791 | Banawali, Fatehabad | Haryana |  |
| Chert Blade | SM-DAM-HR-369826 | Banawali, Fatehabad | Haryana |  |
| Chert Blade | SM-DAM-HR-369827 | Banawali, Fatehabad | Haryana |  |
| Figurine | UM-DCP-MH-504036 | Marmi | Maharashtra |  |
| Chert Blade | SM-DAM-HR-369835 | Banawali, Fatehabad | Haryana |  |
| Chert Blade | SM-DAM-HR-369837 | Banawali, Fatehabad | Haryana |  |
| Chert Blade | SM-DAM-HR-369839 | Banawali, Fatehabad | Haryana |  |
| Chert Blade | SM-DAM-HR-369856 | Banawali, Fatehabad | Haryana |  |
| Chert Blade | SM-DAM-HR-369860 | Banawali, Fatehabad | Haryana |  |
| Chert Blade | SM-DAM-HR-369864 | Banawali, Fatehabad | Haryana |  |
| Chert Blade | SM-DAM-HR-369867 | Banawali, Fatehabad | Haryana |  |
| Chert Blade | SM-DAM-HR-369869 | Banawali, Fatehabad | Haryana |  |
| Chert Blade | SM-DAM-HR-369899 | Banawali, Fatehabad | Haryana |  |
| Chert Blade | SM-DAM-HR-369900 | Banawali, Fatehabad | Haryana |  |
| Chert Blade | SM-DAM-HR-369901 | Banawali, Fatehabad | Haryana |  |
| Arrow Head | GM-DAI-UP-1133980 | Kalli Pachchhim Surface collection | Uttar Pradesh |  |
| Chert Blade | SM-DAM-HR-369931 | Banawali, Fatehabad | Haryana |  |
| Chert Blade | SM-DAM-HR-369941 | Banawali, Fatehabad | Haryana |  |
| Chert Blade | SM-DAM-HR-370142 | Banawali, Fatehabad | Haryana | |
| Point | CAC-CCA-DL-897146 | Pachmarhi, Madhya Pradesh | Delhi |  |
| Rod | GM-EXC-DL-736515 | Dholavira, Dist.- Kutch, Gujarat | Delhi |  |
| Sling ball | CAC-CCA-DL-1066550 | Balirajgarh, Bihar | Delhi |  |
| Blade | CAC-CCA-DL-916877 | Bahal ,Maharashtra | Delhi |  |
| Chert Blade | SM-DAM-HR-370150 | Banawali, Fatehabad | Haryana |  |
| Blade | CAC-CCA-DL-980117 | Maski, Karnataka | Delhi |  |
| Blade | CAC-CCA-DL-980108 | Maski, Karnataka | Delhi |  |
| Blade | UM-DCP-MH-450872 | Bagor, Rajasthan | Maharashtra |  |
| Blade | CAC-CCA-DL-980119 | Maski, Karnataka | Delhi |  |
| Core | CAC-CCA-DL-980148 | Nagri, Rajasthan | Delhi |  |
| Blade | CAC-CCA-DL-980129 | Maski, Karnataka | Delhi |  |
| Raw Material | SM-DAM-HR-374202 | Banawali, Fatehabad | Haryana |  |
| Blade | GM-EXC-DL-736523 | Dholavira, Dist.- Kutch, Gujarat | Delhi |  |
| Drill Bit | GM-EXC-DL-736520 | Dholavira, Dist.- Kutch, Gujarat | Delhi |  |
| Rod | GM-EXC-DL-752163 | Dholavira, Dist.- Kutch, Gujarat | Delhi |  |
| Drill Bit | GM-EXC-DL-752172 | Dholavira, Dist.- Kutch, Gujarat | Delhi |  |
| Flake | UM-DCP-MH-594171 | Bahal BHL , District Jalgaon East Khandesh , Maharashtra | Maharashtra |  |
| Core | UM-DCP-MH-455096 | Bhimbetka, District-Raisen, Madhya Pradesh. | Maharashtra |  |
| Drill Bit | GM-EXC-DL-752175 | Dholavira, Dist.- Kutch, Gujarat | Delhi |  |
| Blade | GM-EXC-DL-736555 | Dholavira, Dist.- Kutch, Gujarat | Delhi |  |
| Blade | CAC-CCA-DL-980161 | Maski, Karnataka | Delhi |  |
| Flake | UM-DCP-MH-490599 | Bhimbetka, District-Raisen, BTK-1973,Trench-IIIF23 Layer - 4. Locus- F3.H3.G2.E3 | Maharashtra |  |
| Flake Core | UM-DCP-MH-447019 | Bagor, Rajasthan, BGR E,F,J,K, 1968-69 | Maharashtra |  |
| Flake | UM-DCP-MH-490624 | Bhimbetka, District-Raisen, BTK-1973,Trench-IIIF23 Layer - 4. Locus- J2.F4.G4 | Maharashtra |  |
| Flake | UM-DCP-MH-490686 | Bhimbetka, District-Raisen, BTK-1973,Trench-IIIF23 Layer - 4. Locus- G3.E4.F2. | Maharashtra |  |
| Flake | UM-DCP-MH-490705 | Bhimbetka, District-Raisen, BTK-1973,Trench-IIIF23 Layer - 4. Locus- E3.F4.L4.J3 | Maharashtra |  |
| Nail | CAC-CCA-DL-912942 | Piprahwa, Uttar Pradesh | Delhi |  |
| Core | UM-DCP-MH-524932 | Bagor, Dist. Bilwara,Rajasthan, BGR . | Maharashtra |  |
| Flakes | UM-DCP-MH-525191 | Bhimbetka, Madhya Pradesh, BTK | Maharashtra |  |
| Cores | UM-DCP-MH-526889 | Bagor, Dist. Bilwara, Rajasthan BGR . | Maharashtra |  |
| Sling ball | CAC-CCA-DL-980126 | Mohenjo-daro, Pakistan | Delhi |  |
| Flake | UM-DCP-MH-490790 | Bhimbetka, District-Raisen, BTK-1973,Trench-IIIF23 Layer - 4. Locus- L4.K2.J1. | Maharashtra |  |
| Flake | UM-DCP-MH-490840 | Bhimbetka, District-Raisen, BTK-1973,Trench-IIIF23 Layer - 4. Locus- G4.E3.J2.L4 | Maharashtra |  |
| © Disclaimer:NMMA may be contacted for any further information. The documented data is under correction and subject to validation. |